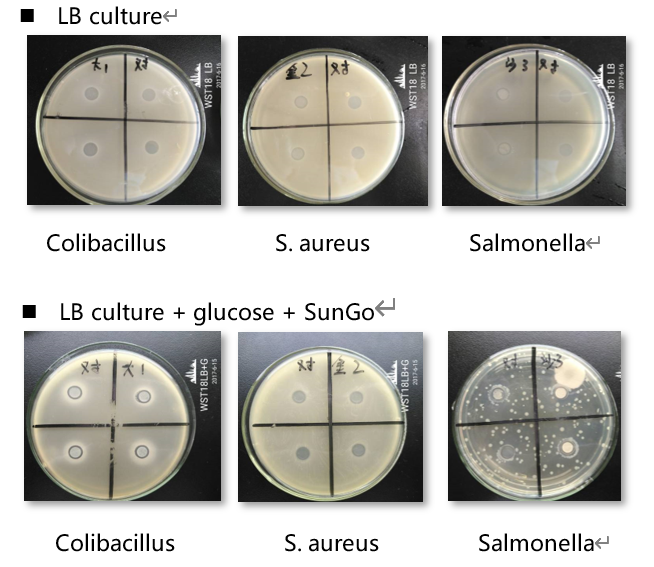

| Sign In | Join Free | My frbiz.com |
|
- Home
- Products
- About Us
- Quality Control
- Contact Us
- Get Quotations
| Sign In | Join Free | My frbiz.com |
|
Brand Name : SunGo
Model Number : 5000 powder
Certification : ISO9001,ISO22000,FAMI-QS
Place of Origin : China
MOQ : 1000 kg
Price : Negotiable
Payment Terms : L/C, D/A, D/P, T/T
Supply Ability : 100MT/month
Delivery Time : Within 30 days
Packaging Details : 25kg/bag, paper plastic bag
Classification : feed grade/enzyme
Technology : submerged fermentation
Activity : 5000 u/g
Origin : microbial source
Color : yellow
Form : powder
SunGo 5000, new generation and thermostable glucose oxidase used as antibiotic replacer
Glucose oxidase, also known as notatin, is a secreted enzyme synthesized predominantly in several species of insects and fungi, which oxidizes glucose into glucolactone, converting oxygen into hydrogen peroxide in the process. Nowadays, glucose oxidase is widely used as feed additives to replace with antibiotics in the feed. SunGo 5000 produced by advanced strain in the world, and performs an excellent catalytic efficiency and thermo-stability by directed evolution and immobilization microencapsulation technology. which can inhibit proliferation of pathogens and improve intestinal health, and strengthen animal immunity.
Anti-bacterial effect (Figure 1)
Table 1. Specification of SunGo 5000
| Name of product | SunGo 5000 | ||
| Activity, U/g | 5000 | Form | Powder |
| Active ingredient | Glucose oxidase | Carrier | Corn starch |
| Appearance | Yellow | Odor | Undetectable |
| Dosage | 100-300g/T feed | Application | Poultry/Swine/Aquaculture/Ruminants feed |
| Place of origin | Wuhan, China 430206 | Shelf-life | 12 months |
| Certification | FAMI-QS, ISO9001, ISO22000 | According to | Q/XHY 05-2018 |
Benefits
Consume oxygen in the GIT, inhibit growth of aerobic bacteria, and intend to healthy intestinal microflora;
Catalyze the reaction which producing gluconic acid, reduce the pH of gastrointestinal tract, promote digestion, and reduce the proliferation of pathogenic;
Use as a substitution of some antibiotics to treat poultry glandular gastritis and diarrhea;
Strengthen immunity and enhance defense function;
Improve feed quality, extend shelf life, improve feed digestibility, and improve growth performance.
Package
25 kg/bag
Shelf-life and Storage
12 months, preserved in cool (<25°C) and dry place.
|
|
Feed Grade 5000u/G Glucose Oxidase Enzyme Powder Form Images |